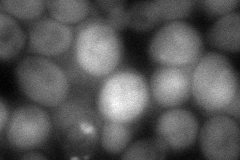
YHR044C
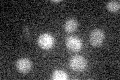
YHR044C

View description
2-deoxyglucose-6-phosphate phosphatase, similar to Dog2p, member of a family of low molecular weight phosphatases; confers 2-deoxyglucose resistance when overexpressed, in vivo substrate has not yet been identified
Localization:
Intensity:
Fold change:
Significance:
-
C’ GFP library in SD

below threshold19.39 -
N' NOP1pr-GFP in SD

cytosol221.915 -
N' TEF2pr-mCherry in SD

cytosol420.656 -
N' NATIVEpr-GFP in SD

below threshold23.2122 -
N' TEF2pr-VC and Cyto-VN in SD
cytosol76.215 -
C’ GFP library in SD+DTT

cytosol23.11.19No -
C’ GFP library in SD+H2O2

cytosol14.380.74No -
C’ GFP library in Starvation Media
cytosol18.080.93No -
C’ GFP library on the background of Pup2-DaMP

below threshold -
C’ GFP library on the background of CCT mutant

below threshold20.89171.07699No
